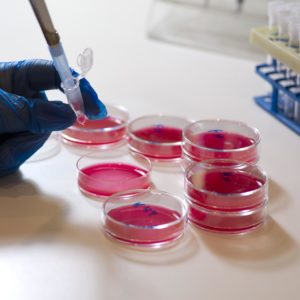
Контроль качества питательных сред

Житковичский районный центр гигиены и эпидемиологии ГУ
ЦГЭ. Осуществление государственного санитарного надзора.
Санэпидемстанции
ЦГЭ. Осуществление государственного санитарного надзора.
Услуги центра гигиены и эпидемиологии

Гигиеническое обучение

Санитарно-гигиенические услуги

Отбор проб, органолептические и физико-химические исследования объектов окружающей среды

Физико-химические исследования продукции

Измерения физических факторов окружающей и производственной среды

Радиологические исследования и измерения

Микробиологические исследования

Проведение санитарно-гигиенических исследований
Исследования клещей

Исследования клещей

Услуги санэпидемстанции

Дезинфекция

Санитарно-микробиологические исследования

Санитарно-паразитологические исследования

Санитарно-эпидемиологический отдел

Санэпидемстанции

Центр гигиены и эпидемиологии

Формирование здорового образа жизни населения

Санитарно-гигиеническая экспертиза
Контроль качества питательных сред
Санитарно-гигиенические услуги

Санитарно-гигиенические услуги

Микробиологические исследования
Контактная информация
- +375 (2353) 5 46 xx (тел.)
-
Пн
 08:00 - 17:00
08:00 - 17:00 13:00 - 14:00
13:00 - 14:00 -
Вт
 08:00 - 17:00
08:00 - 17:00 13:00 - 14:00
13:00 - 14:00 -
Ср
 08:00 - 17:00
08:00 - 17:00 13:00 - 14:00
13:00 - 14:00 -
Чт
 08:00 - 17:00
08:00 - 17:00 13:00 - 14:00
13:00 - 14:00 -
Пт
 08:00 - 17:00
08:00 - 17:00 13:00 - 14:00
13:00 - 14:00 -
СбВыходной
-
ВсВыходной
Контактное лицо

- Имя
- Должность

